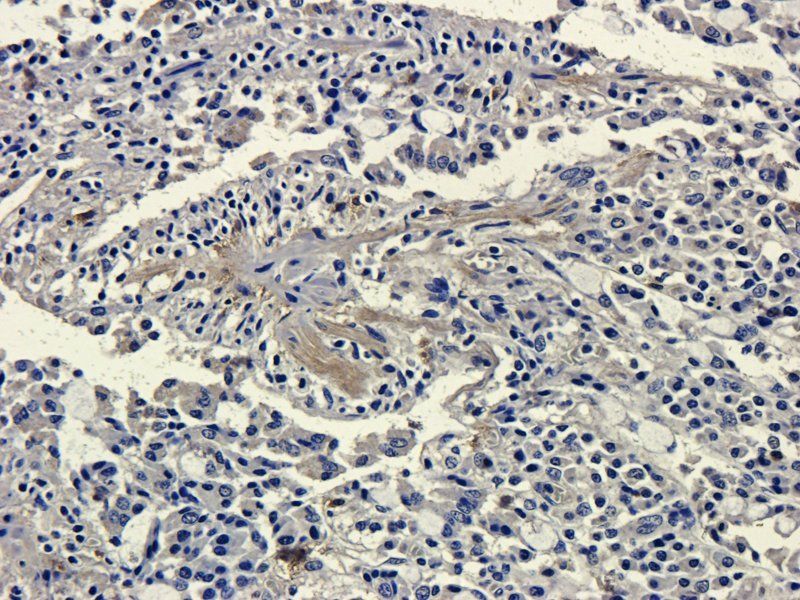
Muc2 antibody
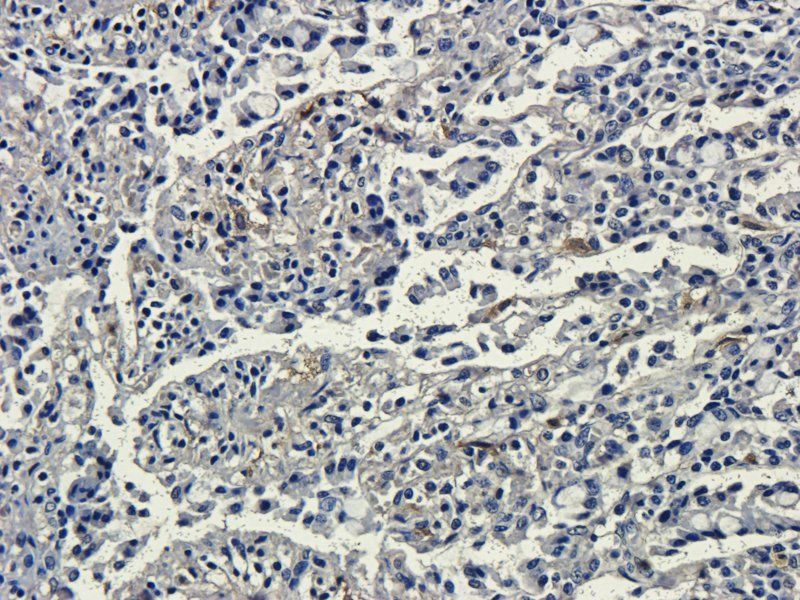
Muc2 antibody
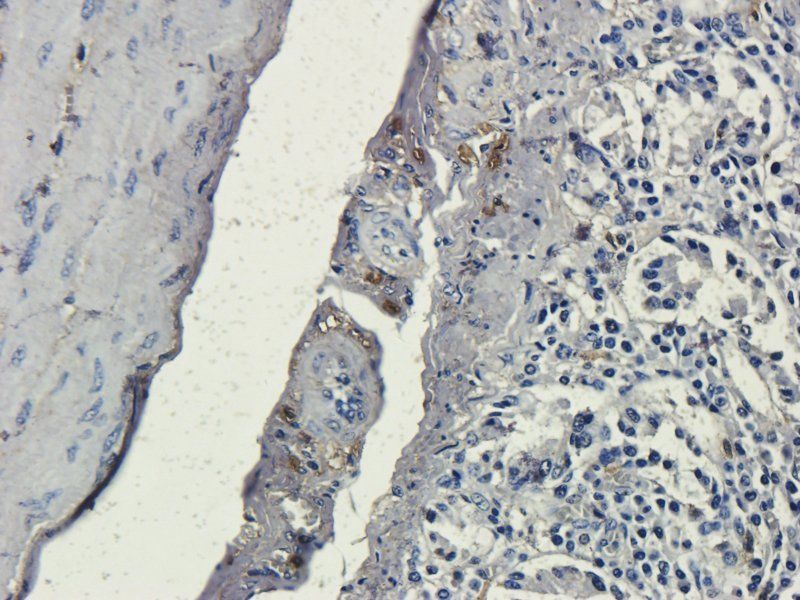
Muc2 antibody
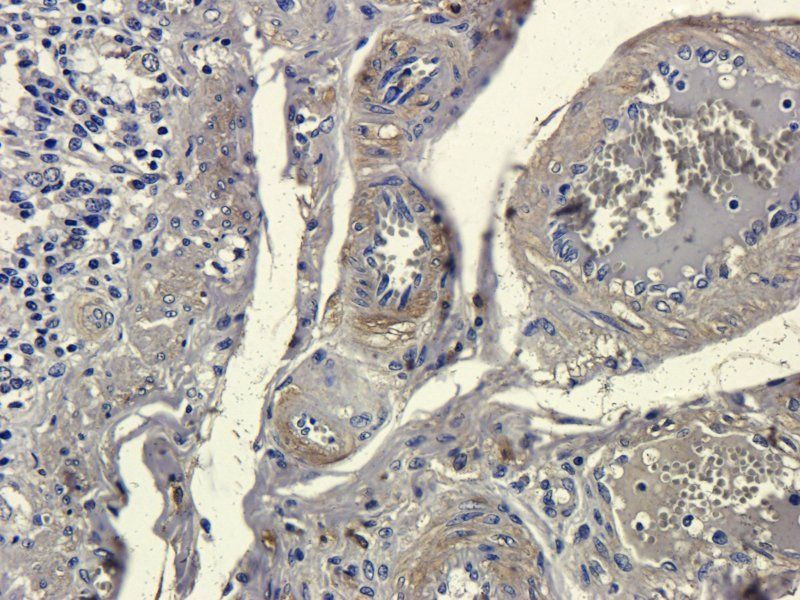
Muc2 antibody

You have no items in your shopping cart.
Muc2 antibody
Description
Images & Validation
−| Tested Applications | ICC, IF, IHC-P |
|---|---|
| Dilution Range | IHC-P: 1:100-500, IF/ICC: 1:100-500 |
| Reactivity | Human, Mouse, Porcine, Rat |
Key Properties
−| Host | Rabbit |
|---|---|
| Clonality | Polyclonal |
| Isotype | IgG |
| Immunogen | KLH conjugated synthetic peptide derived from human Muc2. Please contact us for the exact immunogen sequence. The peptide is available as orb374990. |
| Target | Muc2 |
| Molecular Weight | 540 kDa |
| Purity | Polyclonal antibodies are purified by peptide affinity chromatography |
| Conjugation | Unconjugated |
Storage & Handling
−| Storage | Maintain refrigerated at 2-8°C for up to 2 weeks. For long term storage store at -20°C in small aliquots to prevent freeze-thaw cycles. |
|---|---|
| Form/Appearance | 10 mM PBS, 0.02% sodium azide |
| Concentration | - 100 μg (in 200 μl): 0.5 mg/ml- 200 μg (in 400 μl): 0.5 mg/ml |
| Expiration Date | 12 months from date of receipt. |
| Disclaimer | For research use only |
Alternative Names
−Similar Products
−MUC2 Rabbit Polyclonal Antibody [orb402450]
IF, IHC
Human, Mouse, Rat
Rabbit
Polyclonal
Unconjugated
100 μgMUC2 Recombinant Rabbit Monoclonal Antibody [orb1151989]
FC, IF, IHC-Fr, IHC-P, WB
Mouse, Rat
Human, Rat
Rabbit
Recombinant
Unconjugated
25 μl, 100 μl, 50 μl

Quality Guarantee
Explore bioreagents carefree to elevate your research. All our products are rigorously tested for performance. If a product does not perform as described on its datasheet, our scientific support team will provide expert troubleshooting, a prompt replacement, or a refund. For full details, please see our Terms & Conditions and Buying Guide. Contact us at support@biorbyt.com.

IHC-P image of human breast cancer tissue using Muc2 antibody (2.5 ug/ml)

Immunofluorescence analysis of pig small intestines tissue using Muc2 antibody (2.5 ug/ml)

Immunohistochemical staining of paraffin embedded human breast cancer tissue using anti-Muc2 (2.5 ug/ml)
Immunohistochemical staining of paraffin embedded pig small intestines tissue using Muc2 antibody (2.5 ug/ml)
IHC-P staining of pig small intestines tissue using anti-Muc2 (2.5 ug/ml)
IHC-P staining of pig small intestines tissue using anti-Muc2 (2.5 ug/ml)

Western blot analysis of rat colon (lane 1), mosue stomach (lane 2), rat lung (lane 3), rat skin (lane 4) using Muc2 antibody (1 ug/ml)
Immunohistochemical staining of pig small intestines tissue using Muc2 antibody (2.5 ug/ml)

Immunofluorescence image of pig small intestines tissue using anti-Muc2 (2.5 ug/ml)
Quick Database Links
Documents Download
Request a Document
Protocol Information
Filter by Applications
Filter by Species
Wenjie Tang 1, Yusen Wei 1, Zhixiang Ni 1, Kangwei Hou 1, Xin M Luo 2, Haifeng Wang IgA-mediated control of host-microbial interaction during weaning reaction influences gut inflammation Gut Microbes, 16(1):, :2323220. (2024)
Applications
Reactivity
Jian Zhang 1, Ruonan Tian 2, Jia Liu 3, Jie Yuan 3, Siwen Zhang 4, Zhexu Chi 5, Weiwei Yu 5, Qianzhou Yu 5, Zhen Wang 5, Sheng Chen 5, Mobai Li 5, Dehang Yang 5, Tianyi Hu 5, Qiqi Deng 5, Xiaoyang Lu 5, Yidong Yang 5, Rongbin Zhou 6, Xue Zhang 7, Wanlu Liu 8, Di Wang A two-front nutrient supply environment fuels small intestinal physiology through differential regulation of nutrient absorption and host defense Cell, (2024)
Applications
Reactivity
Zhang, Jian et al. Epithelial Gasdermin D shapes the host-microbial interface by driving mucus layer formation Sci Immunol, 7, (2022)
Applications
Reactivity
Tang, Wenjie et al. Ileum tissue single-cell mRNA sequencing elucidates the cellular architecture of pathophysiological changes associated with weaning in piglets BMC Biol, 20, 123 (2022)
Applications
Reactivity
Muc2 antibody (orb372331)
Participating in our Biorbyt product reviews program enables you to support fellow scientists by sharing your firsthand experience with our products.
Login to Submit a Review
















